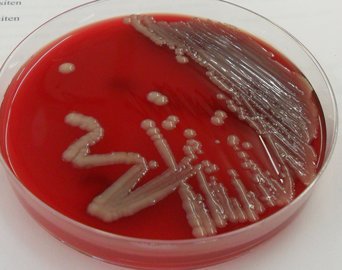
Диетолог Соломатина: бесконтрольный прием антибиотиков опасен пневмонией

Хирург Сюэ: избежать геморроя получится, если проводить в туалете не более 10 минут
 Здоровье
Здоровье
 Здоровье
Здоровье
Доктор Лай Сюэ напомнил об опасности длительного сидения на унитазе для здоровья человека. Как пишет «РГ» со ссылкой на CNN, это может привести к ослаблению тазовых мышц.
Диетолог Елиашевич: сосиски и колбасы вызывают рак толстой кишки
 Здоровье
Здоровье
 Здоровье
Здоровье
Доктор Софья Елиашевич сообщила Life.ru об опасности регулярного потребления переработанных мясных продуктов, включая колбасы и сосиски, которые негативно влияют на здоровье сердца и сосудов.
- Доктор Мясников: пробуждение лунатика во время приступа не вызывает инфаркт
- Эндокринолог Подорожнюк: белый хлеб нужно сочетать с белковой пищей
- Трансплантолог Готье: рак печени – показание для пересадки органа
- Реабилитолог Агапкин: от тромбов спасут чеснок, яблоки и шоколад
- Эндокринолог Казачкова: избыток соли приводит к образованию камней в почках
- Невролог Зинчева: хронический стресс чреват Альцгеймером
- Терапевт Мезенова: пневмония вызывает отказ органов при отсутствии лечения
- Гастроэнтеролог Антюфеева: энергетики опасны гастритом, эрозиями и язвой
- Врач Мясников: стеноз аорты развивается из-за отложения кальция
- Дерматолог Баранова: ежедневное потребление манки приводит к набору веса
Косметолог Баранова: пища из поцарапанной сковороды может вызвать рак
 Здоровье
Здоровье
 Здоровье
Здоровье
Кандидат медицинских наук Ирина Баранова в своем телеграм-канале проинформировала, почему нельзя готовить пищу на поцарапанной сковороде с антипригарным покрытием.
Диетолог Соломатина: бесконтрольный прием антибиотиков опасен пневмонией
 Здоровье
Здоровье
Здоровье
Здоровье
Доктор Елена Соломатина прокомментировала распространение пневмонии. Заболевание поражает российское население по двум причинам, пишет «Узнай.ру».
Врач Раджан: герпес при поцелуе может вызвать судороги у новорожденного
 Здоровье
Здоровье
 Здоровье
Здоровье
Доктор Каран Раджан напомнил о важности соблюдения дистанции между взрослыми и младенцами, чтобы не навредить здоровью малыша. В частности, не стоит целовать новорожденных детей, пишет UfacityNews.
Инфекционист Азнатулина: грибок Candida auris опасен для больных COVID-19
 Здоровье
Здоровье
 Здоровье
Здоровье
Врач Айгуль Азнатулина напомнила россиянам об опасности грибка Candida auris, который в последнее время все сложнее поддается лечению.
- BBI: снижение иммунитета может вызывать депрессию
- Хирург Григорьян: спорт и отказ от каблуков укрепляют сердце
- Диетолог Миркискина: похудеть к Новому году поможет отказ от алкоголя
- Ученые из США: пальмовое масло вызывает прогрессирование рассеянного склероза
- Кардиолог Розанов: для продления жизни важны сон, питание и спорт
- Психолог Полина: избежать лишнего веса зимой помогут фрукты
- Профессор Кондюрина: белковая пища и прогулки защитят ребенка от ОРВИ
- Ученые: COVID-19 привел росту количества зависимых от алкоголя людей
- Диетолог Хобсон: подсолнечное масло полезно за счет омега-6 жирных кислот
- Остеопат Симкин: каблуки противопоказаны при поперечном плоскостопии

